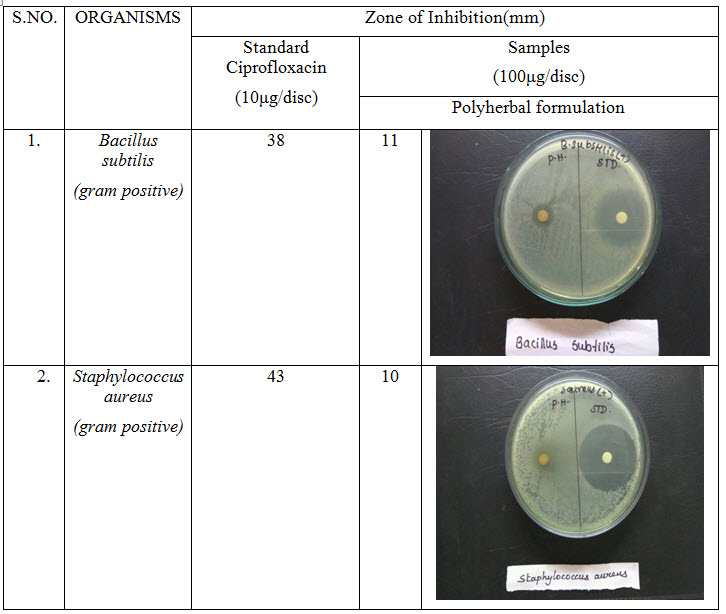
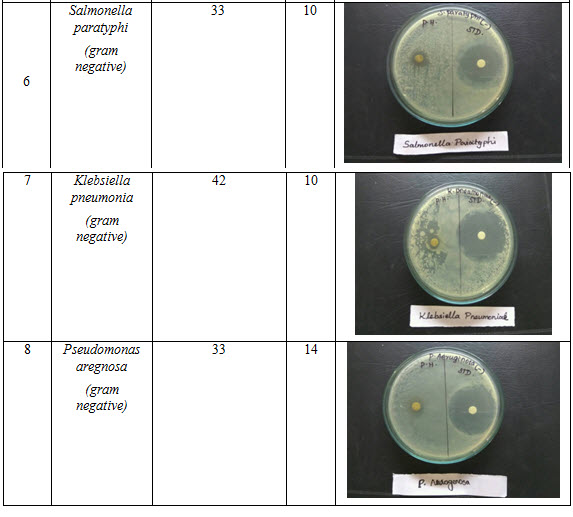
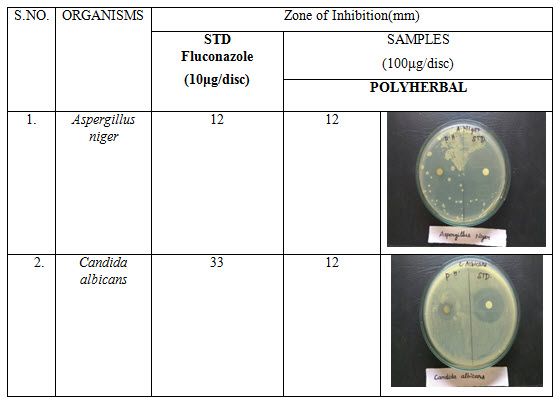

{ DOWNLOAD AS PDF }
ABOUT AUTHORS
*Ramasamy M, Suresh Kumar S, Vishali M, Swetha M, Yuvarani S, Gopala sathees kumar K
KMCH college of Pharmacy, Kovai Estate, Kalapatti Road,
Coimbatore, Tamil Nadu, India
ABSTRACT
Aim and objective: The primary aim of the study is to formulate, standardize and evaluate the polyherbal (Murraya koenigii, Zingiber officinale,n Syzygium cumini, Phyllanthus emblica, Moringa oleifera, Azadirachta indica, Citrous limon) solid dosage form for systemic diseases. Methodology: The polyherbal solid, Dosage form was formulated by filling the polyherbal powder mixture into the hard gelatin capsules, standardized as per WHO guidelines of quality standardization. It was evaluated for antioxidant parameters (DPPH and ABTS assays) and Antimicrobial activity. Results: Pharmaceutical parameters i.e. weight variation; moisture analysis and drug content are within I.P limit. Dissolution studies reveal that the release of maximum drugs (91%) at 120 minutes. The DPPH assay and ABTS assay activity of the polyherbal extract is found to be close to the standard drugs. Antimicrobial activity of polyherbal extract showed zone of inhibition 34mm for E-coli and 12 mm for Aspergillus Niger. The polyherbal drugs are less effective against rest of the microorganisms.
[adsense:336x280:8701650588]
Reference Id: PHARMATUTOR-ART-2615
|
PharmaTutor (Print-ISSN: 2394 - 6679; e-ISSN: 2347 - 7881) Volume 6, Issue 10 Received On: 09/08/2018; Accepted On: 07/09/2018; Published On: 01/10/2018 How to cite this article: M, R., S, S.K., M, V., M, S., S, Y. and K, G. 2018. Formulation, Evaluation of Polyherbal Solid Dosage Form and Study of Its Antimicrobial and Antioxidant Activity. PharmaTutor. 6, 10 (Oct. 2018), 17-25. DOI:https://doi.org/10.29161/PT.v6.i10.2018.17 |
INTRODUCTION
Ayurveda is one of the traditional medicinal systems with an established history of many centuries. Furthermore known as Ayurvedic medicine, this ancient vedic knowledge is considered to be one of the oldest healing sciences and has survived until the present generation over many centuries of tradition. Originated in India thousands of years ago, Ayurveda is known as the ‘mother of all healing’. Etymologically speaking it is the combination of Sanskrit words ayur (life) and veda (science or knowledge), which means “the science of life”, focusing on bringing harmony and balance in all areas of life including mind, body and spirit. In Ayurveda, panchamahabhutas are the five elements: vayu(air), teja(fire), apa(water), prithvi(earth) and akasha(void) are believed to build up the living microcosm (human beings) and the macrocosm(external universe). All these present the constitution or prakriti of an individual which determines the physical as well as mental characteristics of human. The concept is the balance between these three fundamental doshas, whereas imbalance causes diseases. Based on panchamahabhutas and tridosha, the prakriti of an individual is determined and a typical treatment plan can be prescribed according to their unique constitution. (Kshirsagar M et al., 2011) The beliefs of Ayurveda is preventing unnecessary suffering and living a long healthy life. Unlike the allopathic medicines which uses mainly synthetic chemicals designed for specific target receptors and primarily give symptomatic relief, Ayurveda involves the use of the natural means such as diet, herbs, spices, minerals, exercise, meditation, yoga, mental hygiene, sounds, smells and mechano-procedures to eliminate the root cause of the disease by restoring balance, at the same time create a healty life-style to prevent the reoccurrence of the imbalance. Ayurveda is said to be holistic as it aims to integrate and balance body, mind and spirit to prevent illness and promote wellness, longevity, vitality and happiness. (Dahanukar SA 1989)
In living systems, oxidation is a basic part of the normal metabolic process, in which reactive oxygen species and many free radicals are generated. Continuous production of free radicals may cause the structure and function of cell constituents and membranes and can result in neurologic and other disorders like cancer, inflammatory disease, diabetes, asthma, cario vascular, neuro degenerative diseases and premature aging. Hence, the prevention of above condition needs the presence of antioxidants or the free radical scavenging molecules. There is plenty of antioxidant substance present in plants and the free radical scavenging molecules present in them are in the form of phenolic compounds, nitrogen compounds, viamins, terpenoids and some other endogeneous medicine. So to maintain a healthy body, one should always increase the intake of foods rich in anti-oxidant compounds that lower the risk of chronic health problems associated with the above disease conditions.
MATERIALS AND METHODS
Preparation of Polyherbal Capsule
The plant materials (Murraya koenigii, Zingiber officinale,n Syzygium cumini, Phyllanthus emblica, Moringa oleifera, Azadirachta indica, Citrous limon) were separated from earthy and other foreign material; shade dried and powdered using a mill. Polyherbal mixture was prepared using the above mentioned six ingredients in equal ratio (Satyanarayan S et al., 1998).The polyherbal solid, Dosage form was formulated by filling the polyherbal powder mixture into the hard gelatin capsules, standardized as per WHO guidelines of quality standardization.
Characterization of Polyherbal Capsule
The developed polyherbal capsules were characterized for the following physiochemical parameters.
Weight variation test
Test for uniformity of weight was performed as per Indian pharmacopoeia (IP), 2007 (Kumar V et al., 2013). Randomly selected 20 capsules were weighed (individually and together) in a single pan balance. The average weight, variation in the individual capsule and the standard deviation was calculated. IP limit for weight variation in case of capsule weighting more than 300 mg is ± 5%.
Moisture analysis
The capsule blend was weighed, kept in an oven at 1050C and equilibrated. It was reweighed again till three constant readings using moisture balance and moisture content was measured gravimetrically (Chui SH et al., 2013).
Drug content
Test for drug content was carried out as per IP (Kumar V et al., 2013). Twenty capsules were taken and emptied their content in a mortar and pestle. In a volumetric flask, 250 mg of powder was taken and diluted with phosphate buffer (pH 6.8). The absorbance of the solution was measured at 213 nm (λ max of the formulation calculated by scanning the different concentration of it in phosphate buffer pH 6.8 within a range of 200 to 400 nm (Savrikar SS et al., 2010) using UV/visible spectrophotometer (Shimadzu 1601 UV–VIS Spectrophotometer, Japan). The amount of drug present in individual capsule was then estimated using standard calibration curve.
Dissolution study
Dissolution profile of capsule formulation containing polyherbal extract was determined according to USP type-I dissolution tester apparatus (rotating basket) (Thermonix Campbell, Inst. IDN code: PC42). An accurately weighed amount of capsule was placed in USP dissolution basket rotated at 100 ± 5 rpm using phosphate-buffered saline (PBS) (pH= 6.8) as a dissolution medium and temperature was adjusted to 37 0C ± 0.5. 3 ml aliquot of sample was withdrawn at regular time intervals (0, 30, 45, 60, 90 and 120 min) diluted and assayed spectrophotometrically at 213 nm. Meanwhile an equal volume of PBS was added to maintain the constant volume. The cumulative % release was calculated for the formulation from previously constructed calibration curve.
Preparation of dried aqueous extract
100 g of polyherbal mixture was taken in 800ml water and a decoction was prepared as per Sarangdhar Samhita (Anonymous 2007). Decoction was filtered through muslin cloth to obtain 200 ml of aqueous extract, concentrated under vacuum using rotatory evaporator (Superfit, Inst. IDN code: PC50) at 800C for 48 hours in order to remove the water content and obtain the extract in dry solid form. (Gopalasatheeskumar K et al., 2017) The extract was then standardized as per WHO guidelines of quality standardization (Aslan M et al., 2010) and Ayurvedic Pharmacopoeia of India (API) (Kopleman SH et al., 2001).
In Vitro Screening of Antioxidant Activity
DPPH (2, 2-Diphenyl 1-2 picrylhydrazyl) Assay
The antioxidant activity of the extract was measured by Blois method. 0.3mM solution of DPPH in ethanol was prepared and 1ml of this solution was added to 1ml of various concentrations of sample (10, 20, 40, 60, 80 and 100μg/ml) and the reference compound (5, 10, 15, 20, 25, and 30μg/ml), shaken vigorously, left to stand in the dark at room temperature for 30min and then absorbance was measured at 517nm against a blank. Reference compound used here was Quercetin. A control reaction was carried out without the test sample. All the tests were performed in triplicate in order to get the mean values. (Saravanan J et al., 2018) The percentage of inhibition was calculated by comparing the absorbance values of the control and test samples. Antiradical activity was expressed as percentage inhibition (I %) and calculated using the following equation:
Percentage inhibition (I %) = (Abs control- Abs sample /Abs control) X 100
Different sample concentrations were used in order to obtain calibration curves and to calculate the IC50 values. (IC50 - concentration required to obtain a 50% radical scavenging activity).
ABTS Radical Scavenging Assay
ABTS radical scavenging activity of the extract was measured by Rice-Evans method. ABTS was dissolved in water to a 7mM concentration. ABTS radical cation (ABTS*+) was produced by reacting ABTS stock solution with 2.45mM potassium persulfate and allowing the mixture to stand in the dark at room temperature for 12-16 hr before use. The radical was stable in this form for more than 2 days when stored in the dark at room temperature. For the study, ABTS solution was diluted with phosphate buffer saline pH 7.4 (PBS) to an absorbance of 0.70 (± 0.02) at 734nm and equilibrated at 300c. Reference compound used here was Quercetin. After addition of 1ml of diluted ABTS+ solution to various concentrations of sample (5, 10, 15, 20, 25, and 30µg/ml) and reference compound (0.25, 0.5, 0.75, 1, 1.25, and 1.5µg/ml), the reaction mixture was incubated for 6min and then absorbance was measured at 734nm against a blank. A control reaction was carried out without the sample. All the tests were performed in triplicate in order to get the mean values. The percentage inhibition of ABTS+ by the sample was calculated according to the formula:
Percentage inhibition (I %) = (Abs control- Abs sample /Abs control) X 100
Different sample concentrations were used in order to obtain calibration curves and to calculate the IC50 values. (IC50 - concentration required to obtain a 50% radical scavenging activity).
Antibacterial Activity (Boopathi T et al., 2017)
The standardized inoculums is inoculated in the plates prepared earlier (aseptically) by dipping a sterile in the inoculums removing the excess of inoculums by passing by pressing and rotating the swab firmly against the side of the culture tube above the level of the liquid and finally streaking the swab all over the surface of the medium 3 times rotating the plate through an angle of 600 C after each application. Finally pass the swab round the edge of the agar surface. Leave the inoculums to dry at room temperature with the lid closed. Each Petri dish is divided into 2 parts, in each part samples disc such as standard ciprofloxacin and sample disc (discs are soaked overnight in SAMPLE solution) and standard Ciprofloxacin 10µg, are placed in the plate with the help of sterile forceps. Then Petri dishes are placed in the refrigerator at 4º C or at room temperature for 1 hour for diffusion. Incubate at 37 º C for 24 hours. Observe the zone of inhibition produced by samples. Measure it using a scale and record the average of two diameters of each zone of inhibition.
Anti-fungal Activity
The standardized inoculums is inoculated in the plates prepared earlier (aseptically) by dipping a sterile in the inoculums removing the excess of inoculums by passing by pressing and rotating the swab firmly against the side of the culture tube above the level of the liquid and finally streaking the swab all over the surface of the medium 3 times rotating the plate through an angle of 60 ºº C after each application. Finally pass the swab round the edge of the agar surface. Leave the inoculums to dry at room temperature with the lid closed. Each Petri dish is divided into 2 parts, in each part samples disc such as standard fluconazole and sample (100µg) disc (discs are soaked overnight in sample solution) and Standard Fluconazole 10µg, is placed in the plate with the help of sterile forceps. Then Petri dishes are placed in the refrigerator at 4º C or at room temperature for 1 hour for diffusion. Incubate at 28 º C for 48hours. Observe the zone of inhibition produced by different samples. Measure it using a scale and record the average of two diameters of each zone of inhibition.
NOW YOU CAN ALSO PUBLISH YOUR ARTICLE ONLINE.
SUBMIT YOUR ARTICLE/PROJECT AT editor-in-chief@pharmatutor.org
Subscribe to Pharmatutor Alerts by Email
FIND OUT MORE ARTICLES AT OUR DATABASE
RESULTS AND DISCUSSION
Table 1: Dissolution study of Polyherbal formulation
|
TIME (MIN) |
PERCENTAGE RELEASED |
|
15 |
29 |
|
30 |
55 |
|
45 |
64 |
|
60 |
76 |
|
90 |
83 |
|
120 |
91 |

Figure 1: In vitro drug release of Polyherbal formulation

Figure 2: In vitro ABTS Scavenging assay of Polyherbal formulation

Figure 3: In vitro DPPH Scavenging assay of Polyherbal formulation
Table 2: IC50 values of Standard and Polyherbal formulation

Table 3: Antibacterial activity of polyherbal formulation

NOW YOU CAN ALSO PUBLISH YOUR ARTICLE ONLINE.
SUBMIT YOUR ARTICLE/PROJECT AT editor-in-chief@pharmatutor.org
Subscribe to Pharmatutor Alerts by Email
FIND OUT MORE ARTICLES AT OUR DATABASE
Table 4: Antifungal activity of polyherbal formulation
In characterization study of poly herbal capsule results showing that weight variation test (n=20) was with in IP limit, moisture analysis (n = 20) was 3.98+_0.5 and pH (n = 20) was 3.5 +_0.02 and drug content uniformity (n = 20) was within IP limit.
In vitro release of the developed formulation was studied and presented in Figure 1. The release rate of the polyherbal formulation showed a maximum cumulative release of 91 % at the end of the study (120 min.)
In dissolution study the result showing almost 100% drug release at 2 hrs. It may due to poly herbal drugs complexity and need for further studies to improve the drug release.
DPPH radical scavenging or the antioxidant activities of poly herbal extract and Quercetin (taken as the standard) were presented in table I. The poly herbal extract has expressed a noteworthy dose dependent inhibition of DPPH. This influence of antioxidants on DPPH is due to its ability to donate hydrogen. The half inhibition concentration (IC50) of poly herbal extract and Quercetin were 27.07μg/ml and 6.248μg/ml respectively. The potential of Quercetin and poly herbs to scavenge DPPH radical is directly proportional to the concentration. The DPPH assay activity is near to standard as Quercetin.
In this polyherbal capsule containing nine herbs are edible vegetables and each one having natural antioxidant effect and they are defend against oxidative imbalance. The known fact behind in most of the end organ damage is reactive oxygen species followed by oxidative stress. This can be balanced by this poly herbal capsule.
Antibacterial activity of poly herbal extract, Ciprofloxacin (Standard) and Fluconazole (standard for antifungal activity) are presented in table 2. The poly herbal extract has showing good response against E. coli (antibacterial) and Aspergillus niger (antifungal) with zone of inhibition of 34 mm.and12mm. Respectively when compared to the standard drugs (33 mm and 12 mm respectively). Rest of other microbesthe zone will be moderately inhibited by poly herbal extract when compared to the standard drugs.
Out of nine herbs particularly Neem, Moringa and Ginger possess antibacterial and anti-fungal activity. The rest of the herbs may be potentiate the anti-microbial activity of Neem and others which is reflected in this study by the zone of inhibition almost equal to standard drug particularly E.Coli and Aspergillus niger.
CONCLUSION
Polyherbal capsule are compact formulation and follow the long way treatment strategies to treat the many disorder like cardiovascular, cancer, inflammatory, ulcer, diabetes and infectious. Also polyherbs are improving the immune system and iron level in hemoglobin. In this study result showed that antioxidant and antimicrobial efficacy and further study need to be focused on preclinical evaluation for pharmacological finding.
REFERENCES
1. Aslan M, Orhan N, Orhan DD, Ergun F (2010); Hypoglycemic activity and antioxidant potential of some medicinal plants traditionally used in Turkey for diabetes; J Ethnopharmacol; 128(2); 384-389
2. Boopathi T, Gopalasatheeskumar K, Parthiban S, Sangeetha G, Thanga Kokila M, Manimaran T (2017); Evaluation of Antimicrobial Activity of Tecoma Stans and Muntingia Calabura; World Journal of Pharmaceutical Research; 6(3) ; 617-627
3. Chui SH, Wong YH, Chio HI, Fong MY, Chiu YM, Szeto YT, Vong WT, Lam CW (2013); Study of heavy metal poisoning in frequent users of Chinese medicines in Hong; Kong and Macau; Phyt-other Res; Vol. 27(6) ; 859-863
4. Dahanukar SA, Thatte UM. Bombay: Popular Prakashan; 1989. Ayurveda Revisited.
5. Gopalasatheeskumar K, Parthiban S, Manimaran T, Boopathi T (2017); Phytochemical Screening on Various Extracts (Benzene, Ethanolic and Aqueous) of Stem Parts of Zanthoxylum Rhetsa (Roxb.) Dc; International Journal of Universal Pharmacy and Bio Sciences; 6(2) ; 79-91
6. Kopleman SH, Nguyen Pho A, Zito WS, Muller FX, Augsburger LL (2001); Selected physical and chemical properties of commercial Hypericum perforatum extracts relevant for formulated product quality and performance; AAPS PharmSci; 3(4) ; 1–18
7. Kshirsagar M, Magno AC. USA: Lotus Press; (2011) ; Ayurveda-A quick reference handbook.
8. Kumar V, Sharma RK, Arora R (2013); Evidence based herbal drug standardization approach in coping with challenges of holistic management of diabetes, a dreadful lifestyle disorder of 21st century; J Diabetes MetabDisord;12-35
9. Saravanan J, Neethu Devasia, Gopalasatheeskumar K, Sanish Devan V, Thanga Kokila K, Sanjay M (2018); Anti-Inflammatory, Antipyretic And Antibacterial Study of Kabasura kudineer choornam; International Journal of Current Advanced Research; 7(2); 9992-9997.
10. Satyanarayan S, Kasinatha S, Chaturvedi G (1998); CharakaSamhita. Chaukhamba Bharati Academy, Varanasi, India.
11. Savrikar SS, Ravishankar B, Bhaishajya Kalpanaa (2010); The Ayurvedic pharmaceutics – an overview; Afr J Tradit Complement Altern Med; 7(3) ; 174-184
NOW YOU CAN ALSO PUBLISH YOUR ARTICLE ONLINE.
SUBMIT YOUR ARTICLE/PROJECT AT editor-in-chief@pharmatutor.org
Subscribe to Pharmatutor Alerts by Email
FIND OUT MORE ARTICLES AT OUR DATABASE

